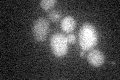
YLR411W
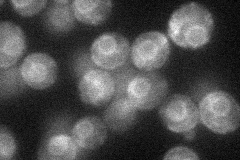
YLR411W
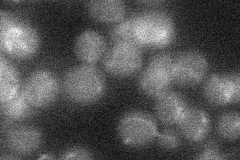
YLR411W
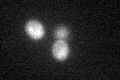
YLR411W

View description
High-affinity copper transporter of the plasma membrane, acts as a trimer; gene is disrupted by a Ty2 transposon insertion in many laboratory strains of S. cerevisiae
Localization:
Intensity:
Fold change:
Significance:
-
C’ GFP library in SD
below threshold15.35 -
N' NOP1pr-GFP in SD
ER32.0534 -
N' TEF2pr-mCherry in SD

ER25.6372 -
N' NATIVEpr-GFP in SD
below threshold13.6048 -
N' TEF2pr-VC and Cyto-VN in SD

#N/A0 -
C’ GFP library in SD+DTT
cytosol15.631.01No -
C’ GFP library in SD+H2O2

cytosol15.180.98No -
C’ GFP library in Starvation Media

cytosol16.691.08No -
C’ GFP library on the background of Pup2-DaMP

below threshold -
C’ GFP library on the background of CCT mutant

below threshold15.12010.984549No
